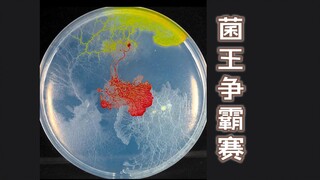
Mushroom King Competition

3. Thời Kỳ Bắc Thuộc 207 TCN - 905
7/91

20:07
7 Đại Việt kiêu hùng - Hai Bà Trưng dựng cờ khởi nghĩa
1 View
2

20:23
8 Đại Việt kiêu hùng - Hai Bà Trưng giao chiến với Mã Viện, Truyện Trương Trọng
0 View
3

20:35
9 Đại Việt kiêu hùng - Khởi nghĩa bà Triệu năm 248 ( Triệu Thị Trinh )
0 View
4

20:30
10 Đại Việt kiêu hùng - Khởi nghĩa Lý Bí năm 542 - Nhà nước Vạn Xuân phần 1
0 View
5

20:33
11 Đại Việt kiêu hùng - Lý Nam Đế giao chiến với Trần Bá Tiên - Nhà nước Vạn Xuân phần 2
0 View
6

16:59
12 Đại Việt kiêu hùng - Triệu Việt Vương cuộc chiến đầm Dạ Trạch - Nhà nước Vạn Xuân phần 3
0 View
7

16:54
13 Đại Việt kiêu hùng - Khởi nghĩa Mai Thúc Loan năm 722
0 View
8

19:44
14 Đại Việt kiêu hùng - Khởi nghĩa Phùng Hưng
0 View
9

13:31
15 Đại Việt kiêu hùng - Khởi nghĩa Dương Thanh năm 819
0 View
Recommended for You
- All
- Anime

![[Bilibili] Teaching You How to Export Videos from the New Cache](https://pic.bstarstatic.com/ugc/2021b3b83f8e1cf9d548ae6d117690a7.jpeg@320w_180h_1e_1c_90q)

![{{Complete}}™ {[List]} of Emirates Airlin® CUSTOMER© SERVICE℗ Numbers — 24/7 Live Person Assistance](https://pic.bstarstatic.com/ugc/75c492f6e854d603eba9026e9dba3e33.jpg@320w_180h_1e_1c_90q)

![{{Complete}}™ {[List]} of Malaysia Airline𝖘® customer© SUPPORT℗ Contact Numbers Person Assistance](https://pic.bstarstatic.com/ugc/7cda898055f2726458375eb4d0a0f2dc.jpg@320w_180h_1e_1c_90q)





